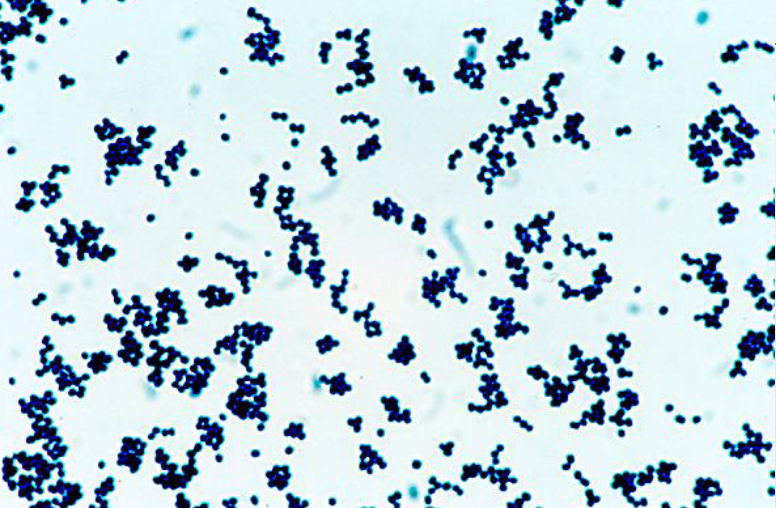
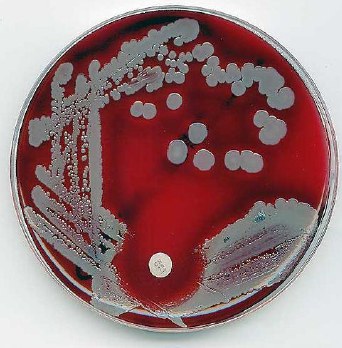

Quelle est la prévalence de S. aureus ?
Qui le S. aureus infecte-il?
Quels 3 types d’infections peuvent être causées par S. aureus ?
Infections post-opératoires
⇒
Décolonisation ciblée associée à une diminution de 45% des infections de sites opératoires
Infections de la peau, des tissus mous, des os et des articulations
Infections invasives
Nommer 3 types d’infections invasives causées par S. aureus
Quelle est la morphologie de S. aureus ? (4 caractéristiques)
Quel est l’autre nom donné à S aureus?
Staphylocoque doré
Quel est l’aspect de S.aureus au microscope?
Coloration de gram
Quel est l’Aspect de S. aureus sur Gélose sanguine?
Dans quels milieux S. aureus peut-elle survivre (3)?
Bactérie coriace:
Quel est le genre de S. aureus?
Staphylococus
Regroupe une trentaine d’espèce au total
Nommer 4 espèces de staphylococus
- Staphylococcus epidermidis
(germe opportuniste, infection reliée au matériel prosthétique)
Différencier les parois bactériennes à gram positif et gram négatif

De quoi est composée la surface bactérienne? (3)
Quel est le rôle de la capsule polysaccharidique à la surface bactérienne?
Antiphagocytaire
Quels sont les 2 rôles des adhésines à la surface bactérienne?
De quoi est composé le biofilm à la surface bactérienne, et quels sont ses 2 rôles?
Composé d’une matrice de protéines et de polysaccharides
Quels sont les trois composants de la paroi de S. aureus?
Quels sont les rôles des AT et ALT de la paroi bactérienne?
Quel sont les 2 rôles des peptidoglycans de la paroi bactérienne?
Rigidité
⇒
Plus de 10 couches chez Gram positifs vs 2 chez Gram négatifs (rigidité)
Inflammation
⇒
Reconnu par le système immunitaire (cytokines)
Quel est le rôle des protéines de surface A de la paroi bactérienne?
Capacité anti-phagocytaire
⇒
Cache le peptidoglycane du système immunitaire
Schématiser la paroi du S. aureus

De quel type sont les toxines de S. aureus?
Ce sont des hémolysines
Quel est le rôle des hémolysines?
Elles lysent la cellule hôte et relâche les cytokines
Quels sont les 4 types d’hémolysines